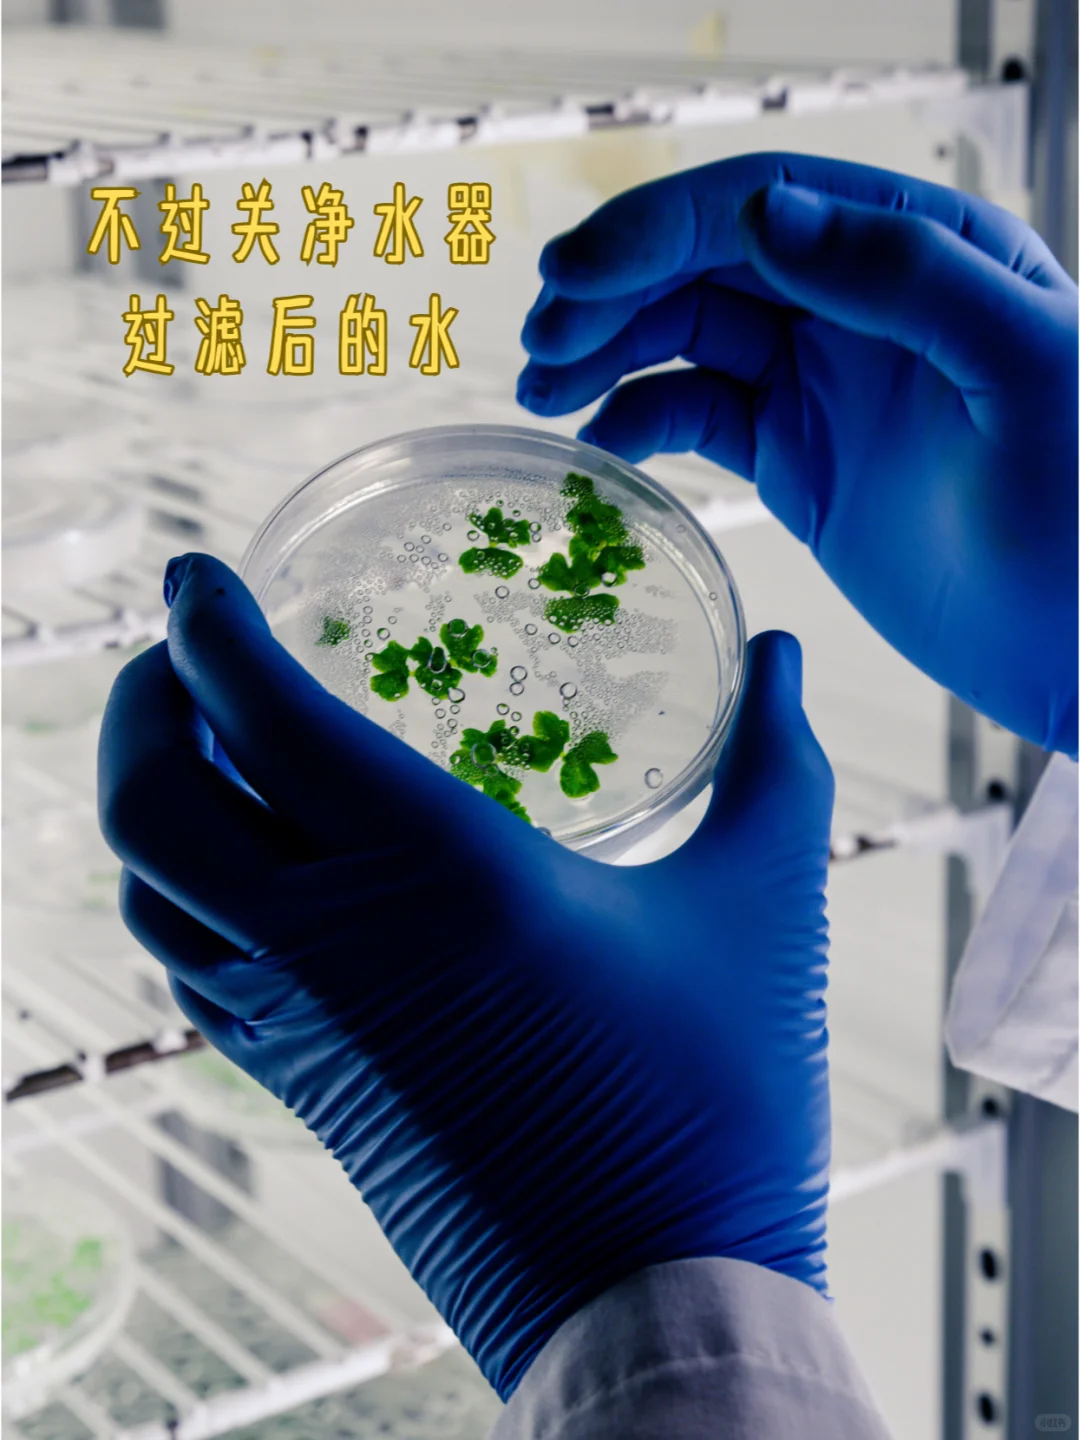

我家的净水器又坏了。
所幸还在质保期,于是就联系了售后师傅上门,看看到底是哪里出了问题。

没想到,和售后师傅的一番闲聊,让我恍然大悟:净水器并不是必选家电。

自来水到底要不要加净水器,选什么样的净水器?
主要看水质、钱包!

选错了净水器不仅无法改善水质,守护用户的健康,反而可能成为“累赘”,害人又害己,对身体健康不利。


售后师傅提醒我:
如果纠结到底要不要安装净水器,就先自查一下水质,若水质达到了安全饮用的标准,就根据自己的喜好决定是否装。

若水质存在着安全隐患,比如,老旧管道腐蚀、二次供水设施的污染……,则根据自己的经济实力选择适合的净水器。

建议,水质偏硬,含有大量的钙镁离子,每次烧水后都会在电器里面形成水垢,口感差,就优选直饮净水器+前置过滤器。

水质较为清澈,但存在重金属污染、细菌、病毒等,不管有钱没钱,一定要安装直饮净水器,确保水质健康。

尤其是有直饮水习惯的家庭,要么直接用桶装水、矿泉水来代替自来水,要么就烧开水之后再喝,或者用TDS笔检测数值低于50都必须立马安装直饮净水器。


若非必要,千万不要装超滤和纳滤净水器,使用成本比前置过滤器高,但过滤后的水达不到直饮的标准。

而且直饮净水器虽然可以去除水中的大颗粒杂质以及重金属离子等有害物质,但并非万无一失。

如,劣质的净水器会直接污染自来水,析出有害物质,危害人体健康;
使用的时间长了,没有及时的更换和清洁滤芯,滤芯就会污染水……

所以想要安装直饮净水器,除了看水质和自己的钱包是否允许之外,在挑选时也要擦亮眼睛,选对不选贵。

如何选购直饮净水器?
1、核心过滤技术
直饮净水器,又名:反渗透净水器。
这是因为它是通过“RO反渗透滤芯”将水中的杂质全过滤掉,让净水器的过滤精细度达到0.0001μm,让自来水变成纯净水。

所以大家如果想要购买直饮净水器,一定要认准带有反渗透过滤技术的产品。

它和常见的超滤、纳滤净水器相比,过滤精细度更高,同时购买使用成本也更高。

因为直饮净水器需要插电才能运行,会产生30~50%的废水。

2、看滤芯配置和更换成本
净水器并不只有ro反渗透滤芯,还有前置活性炭、pp棉等滤芯作为辅助,使其达到更好的过滤效果,间接的延长渗透滤芯的使用寿命,降低使用直饮净水器的成本。

建议,若不是土豪,一定要提前了解净水器的滤芯组合,在预算范围内选择配置更高、使用成本更低的产品。

如,预算有限就选择滤芯为“pp棉+前置活性炭+RO膜+后置活性炭”配置的直饮净水器,既能保证过滤彻底,直饮水口感好。

预算充沛,想要长时间使用直饮净水器,则可以优先考虑选择滤芯为“UF膜+RO膜”配置的直饮净水器,虽然买着略贵,但从长久来看,更经济实用。

并且提前了解净水器滤芯的更换周期和费用,以免后期用不起,不得不闲置。

3、看水效等级/废水比
水效等级代表着水资源的利用效率,通常一级水效产品比其他等级更节能环保。

但相对的,一级水效的价格可能略贵。
因而,建议,买净水器的时候一定要想清楚,如果是短暂的过度,可以选择2级水效的产品,若长期用,一定要认准1级水效。

不过需要注意:如今市面上的净水器品牌众多,品质良莠不齐,鱼龙混杂,即使是1级能效的产品,净水比可能也大相径庭。

净水比越小,不代表越节能。
大家最好选择废水和净化水比例为1:2或1:3的产品,它们整体性价比更高。

4、看通量
通量代表着净水器单位时间内产生净水的数量,能直接影响到日常用水的效率。

为此,不少销售人员都建议“选择通量更大的产品”,甚至直言:通量越大越好。

但实际上,通量大的产品能节省等待的时间,提升家庭用水效率,相对的,净水器的使用和购买成本也会越高。

建议大家,不要盲目贪大,要根据实际的用水需求选择适合的产品。
如,三口之家优选400G以上的,如果选择通量小的,担心要长时间等待,还可以额外的配置储水桶,以防万一。


5、看出水方式
净水器的出水方式可以选单出水或双出水,然后根据习惯和经济实力合理安排纯水和净水的使用场景。

建议,优先选双出水。
一方面是因为纯水不适合长时间饮用,饮用的时间长了会导致人体缺少必要的微量元素,出现各种不适症状。

另外则是因为双出水可以出纯水和净水,最大限度上保护水资源和降低使用成本。

6、选带智能数显tds值
通常自来水会受到地下水管、水箱、当地的土质等各方面的污染,随时发生变化。

而绝大多数人根本无法通过口感来辨别水质是否变差,是否该更换滤芯……

所以如果不想误饮到已经遭到污染、达不到直饮标准的自来水,最好选择带有智能数显tds值的产品,随时监测水质的变化,做到及时更换和清洁净水器的滤芯。

7、注意附加功能
随着时代的发展,市面上出现了许多中高端的净水器,它们和基础款的净水器相比,功能更多,用着更便利,可以更好的防范污染水成为日常饮用水。

因而,建议大家,在经济实力允许的范围内,一定要挑最贵的买,不止如此,如果可以,尽量选附加功能多一些的产品。

如,零陈水设计、滤芯更换提醒……
它们都能或多或少的影响到净水器的使用以及水质,成为“健康的守护神”。

尤其是零陈水设计,如果没有这个设计,那么经过一晚上的静置,净水器放出的第一杯水可能已经达不到直饮标准,每天早晨用水之前就必须先放水,放一段时间后才能作为饮用水。

8、选知名品牌
建议,不管预算多少,只要买净水器就一定要认准品质和售后有保障的知名品牌。

写在最后,
以上就是关于净水器的全部内容,大家如果有不同的看法,欢迎留言,希望我的分享对你有帮助。
部分参考图片来源自网络,未查明出处,如有问题,请私信联系删除。